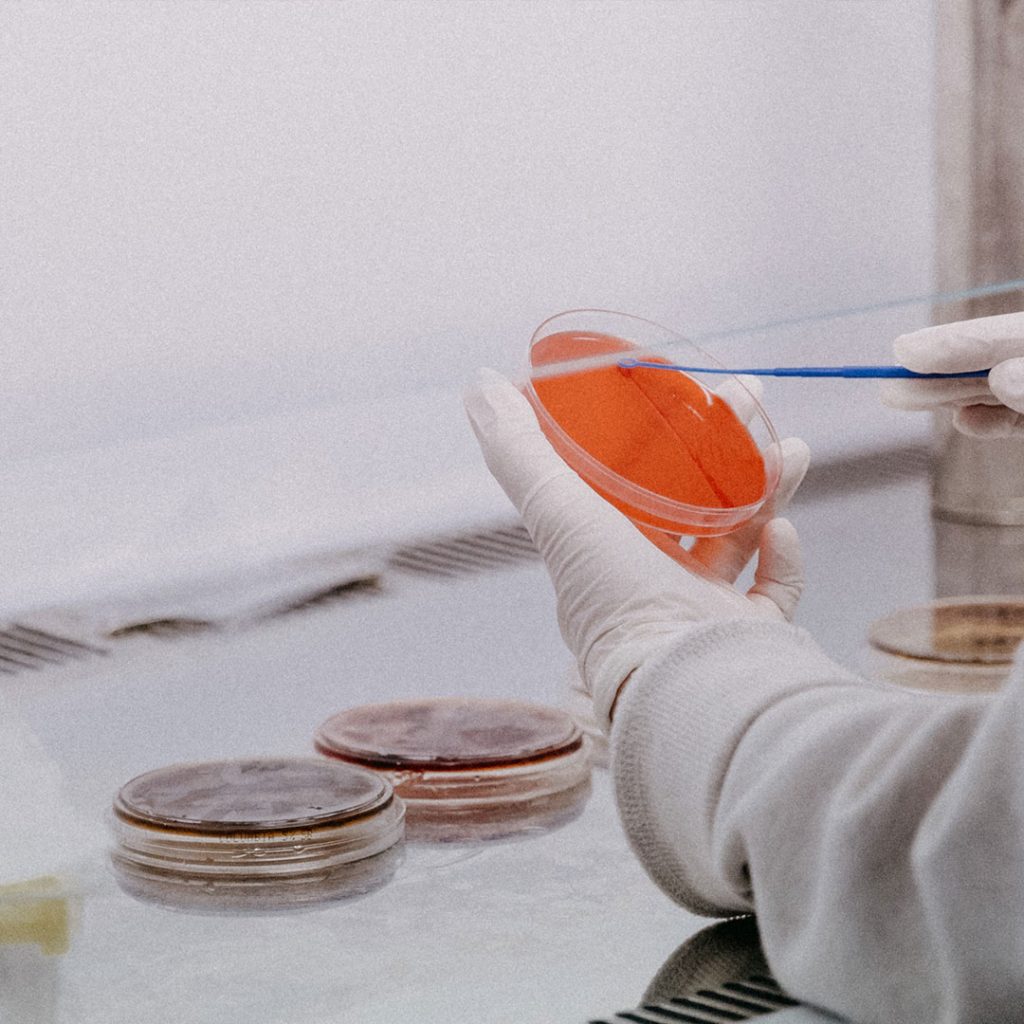

UNAIR NEWS – Fakultas Sains dan Teknologi (FST) Universitas Airlangga kembali membagikan informasi dan prestasi terkini kepada para calon mahasiswa baru. Tepatnya melalui Info Session FST UNAIR dalam Airlangga Education Expo (AEE) pada Minggu (20/2/2022) via Zoom Meeting.
Dekan Prof Dr Moh Yasin MSi menyebut FST UNAIR merupakan salah satu fakultas terbaik di UNAIR. Berdiri sejak 1982, fakultas yang awalnya bernama FMIPA itu kini memiliki delapan program studi (prodi) jenjang sarjana (S1); 3 prodi magister (S2); dan 1 prodi doktor (S3).
“Tidak sedikit lulusan (FST UNAIR, Red) telah berkiprah dan berprestasi di tingkat nasional maupun internasional,” ujarnya.

Budaya Inovasi
FST UNAIR juga telah banyak menelurkan inovasi bidang sains dan teknologi melalui segudang publikasi serta produk karya. Salah satu inovasi karya FST UNAIR itu, lanjur Prof Yamin, adalah alat terapi pasca stroke.
Karya tersebut merupakan inovasi hasil dari prodi S1 Teknik Biomedik. Dalam waktu dekat, karya inovasi itu akan dipamerkan di Rumah Sakit Universitas Airlangga (RSUA).
“Bukan hanya itu, pengembangan Vaksin Merah Putih yang kini tengah menjalani proses uji klinis juga berkat kontribusi dari prodi Kimia UNAIR,” katanya.
Berkenaan dengan profil alumni, sebut Prof Yamin, lulusan FST UNAIR memiliki prospek kerja yang luas dan fleksibel. Mengingat, keilmuan di FST UNAIR terdiri atas bidang-bidang fundamental di dunia sains dan teknologi.
Kebutuhan Fisikawan
Prof Yasin menyebutkan bahwa saat ini terdapat kebutuhan yang tidak sedikit terkait fisikawan medis. Mengingat, seluruh dunia tengah dihadapkan pada problem-problem kesehatan seperti Covid-19.
“Profil lulusan kami juga banyak yang menjadi fisikawan industri, peneliti, birokrat pendidik. Bahkan menteri kesehatan kita juga lulusan dari Fakultas Sains dan Teknologi,” katanya.
Akreditasi Internasional
Sementara itu, Wakil Dekan II FST UNAIR, Dr Miratul Khasanah menyebut FST UNAIR sangat berkomitmen kepada kualitas pendidikan dan lulusan. Sebanyak empat prodi telah terakreditasi internasional.
”Banyak pula program internasional yang tersedia di FST UNAIR,” ucapnya.
Saat ini empat prodi FST UNAIR terakreditasi oleh EUN-QA. Yakni, akreditasi dari ASEAN. Termasuk prodi telah terakreditasi ASIIN, yaitu akreditasi internasional di bidang teknik, ilmu alam, matematika, kedokteran dan ekonomi.
“Tentu banyak kualifikasi (indikator akreditasi). Salah satunya, fasilitas, serta program dan sistem pembelajaran,” katanya.
“Termasuk dinilai dari serapan lulusan di pasar kerja. Kami bersyukur sudah memenuhi itu,” imbuh Dr Miratul.
Student Exchange
FST UNAIR terus mendorong peningkatan program internasional bagi mahasiswa. Khususnya perihal pengembangan keilmuan dan kualitas lulusan.
Beberapa program internasional di FST UNAIR adalah student exchange, student outbound, dan KKN (Kuliah Kerja Nyata) Internasional. Program tersebut diharapkan mampu memberikan global exposure mahasiswa sehingga memiliki standar kualitas internasional.
“Pada 2020 kami menghadirkan enam Adjunct Professor untuk memperkuat riset dan publikasi. Mereka juga memberikan kuliah kepada mahasiswa. Jadi, mahasiswa berkesempatan belajar langsung dari profesor kelas dunia,” ucap Dr Miratul. (*)
Penulis: Ivan Syahrial Abidin
Editor: Feri Fenoria